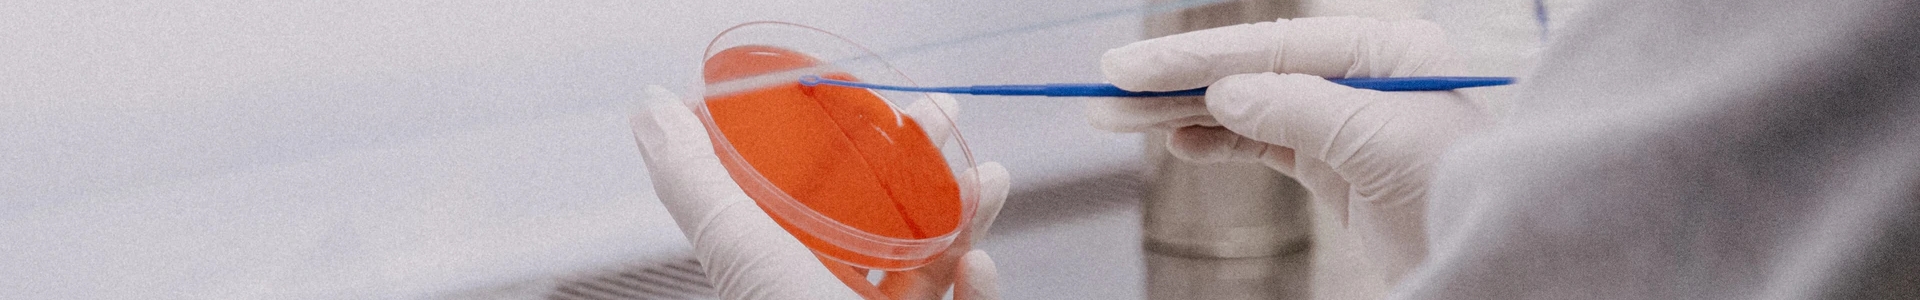

NANOPARTICLE DETECTION
了解微納米粒檢測技術在各個測試環境下的應用
TECHNOLOGY INTRODUCTION
微納米粒檢測實驗室目前具有以下儀器,主要應用于溶液中固體荷電性質測試、表面張力性質測試、表面活性物質表面特性測試和樣品的粒度分布和顆粒濃度測試等。儀器包括:JS94K 增強型微電泳儀(圖1)JK99C 全自動張力儀(圖1)JMP2000A 界面膨脹流變儀(圖1)和AccuSizer 780 APS 全自動計數粒度儀(圖2)。

圖1 微納米粒檢測實驗室主要儀器(JS94K 增強型微電泳儀、JK99C 全自動張力儀、JMP2000A 界面膨脹流變儀)

圖2微納米粒檢測實驗室主要儀器(AccuSizer 780 APS 全自動計數粒度儀)